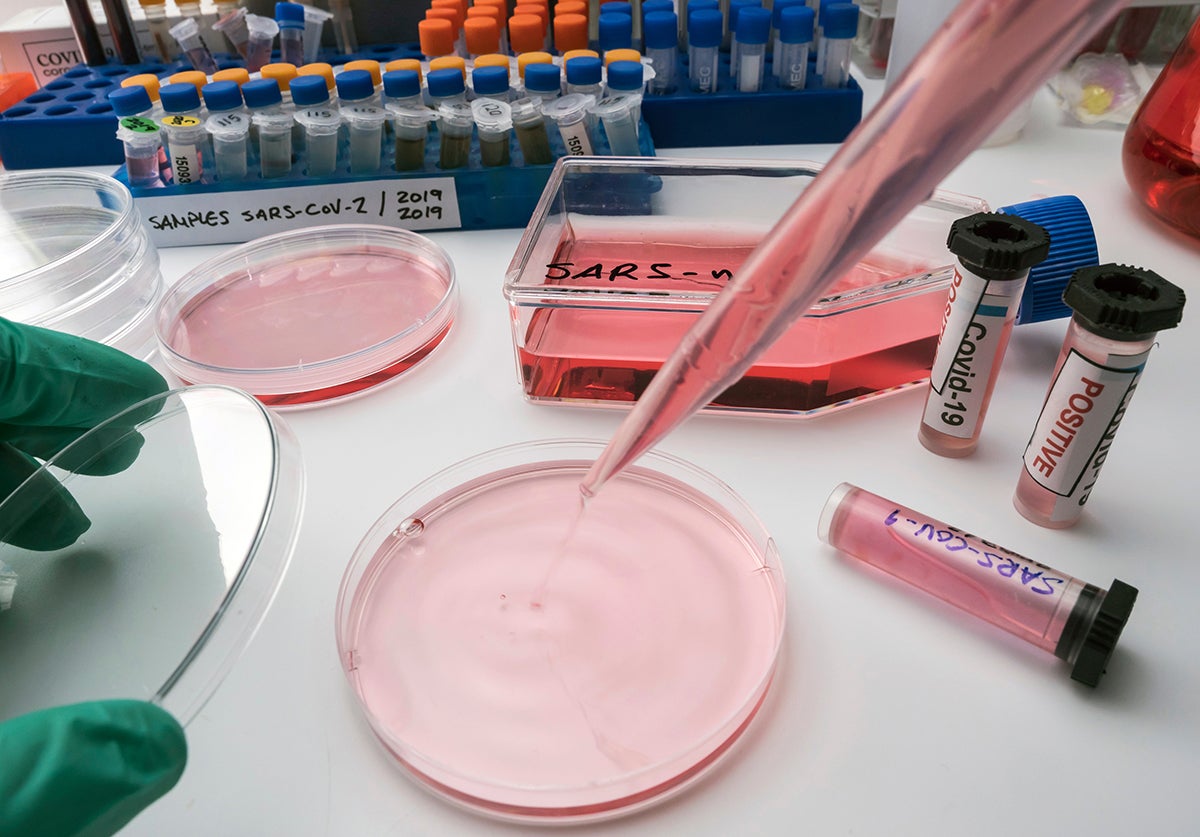
Banner Image

Therapeutic approaches to SARS-CoV-2 infection are moving from conjectural to evidence based and from supportive to active antivirals or immunomodulatory therapies. Randomised Controlled Trials (RCTs) have shown survival benefit for low dose dexamethasone in hospitalised patients.
Remdesivir, a nucleoside analogue antiviral, reduces the duration of symptoms and hospital stays in RCTs. Use of convalescent blood plasma and interferon beta seem to be approaches with the most promise but RCTs are lacking. In contrast, monotherapy with hydroxychloroquine, or lopinavir/ritonavir, have been shown to be ineffective in hospitalized patients.
Many questions remain, such as the appropriate timing of the initiation of treatments, which patient sub groups benefit most from specific therapies, treatment of elderly or community patients, and the value of combination therapies. Where possible, COVID-19 therapies should be delivered in a clinical trials setting, so valid conclusions can be made about their future role.
Speaker
Dr. Alasdair MacGowan
Antimicrobial Therapeutics at the University of Bristol, UK
Biography